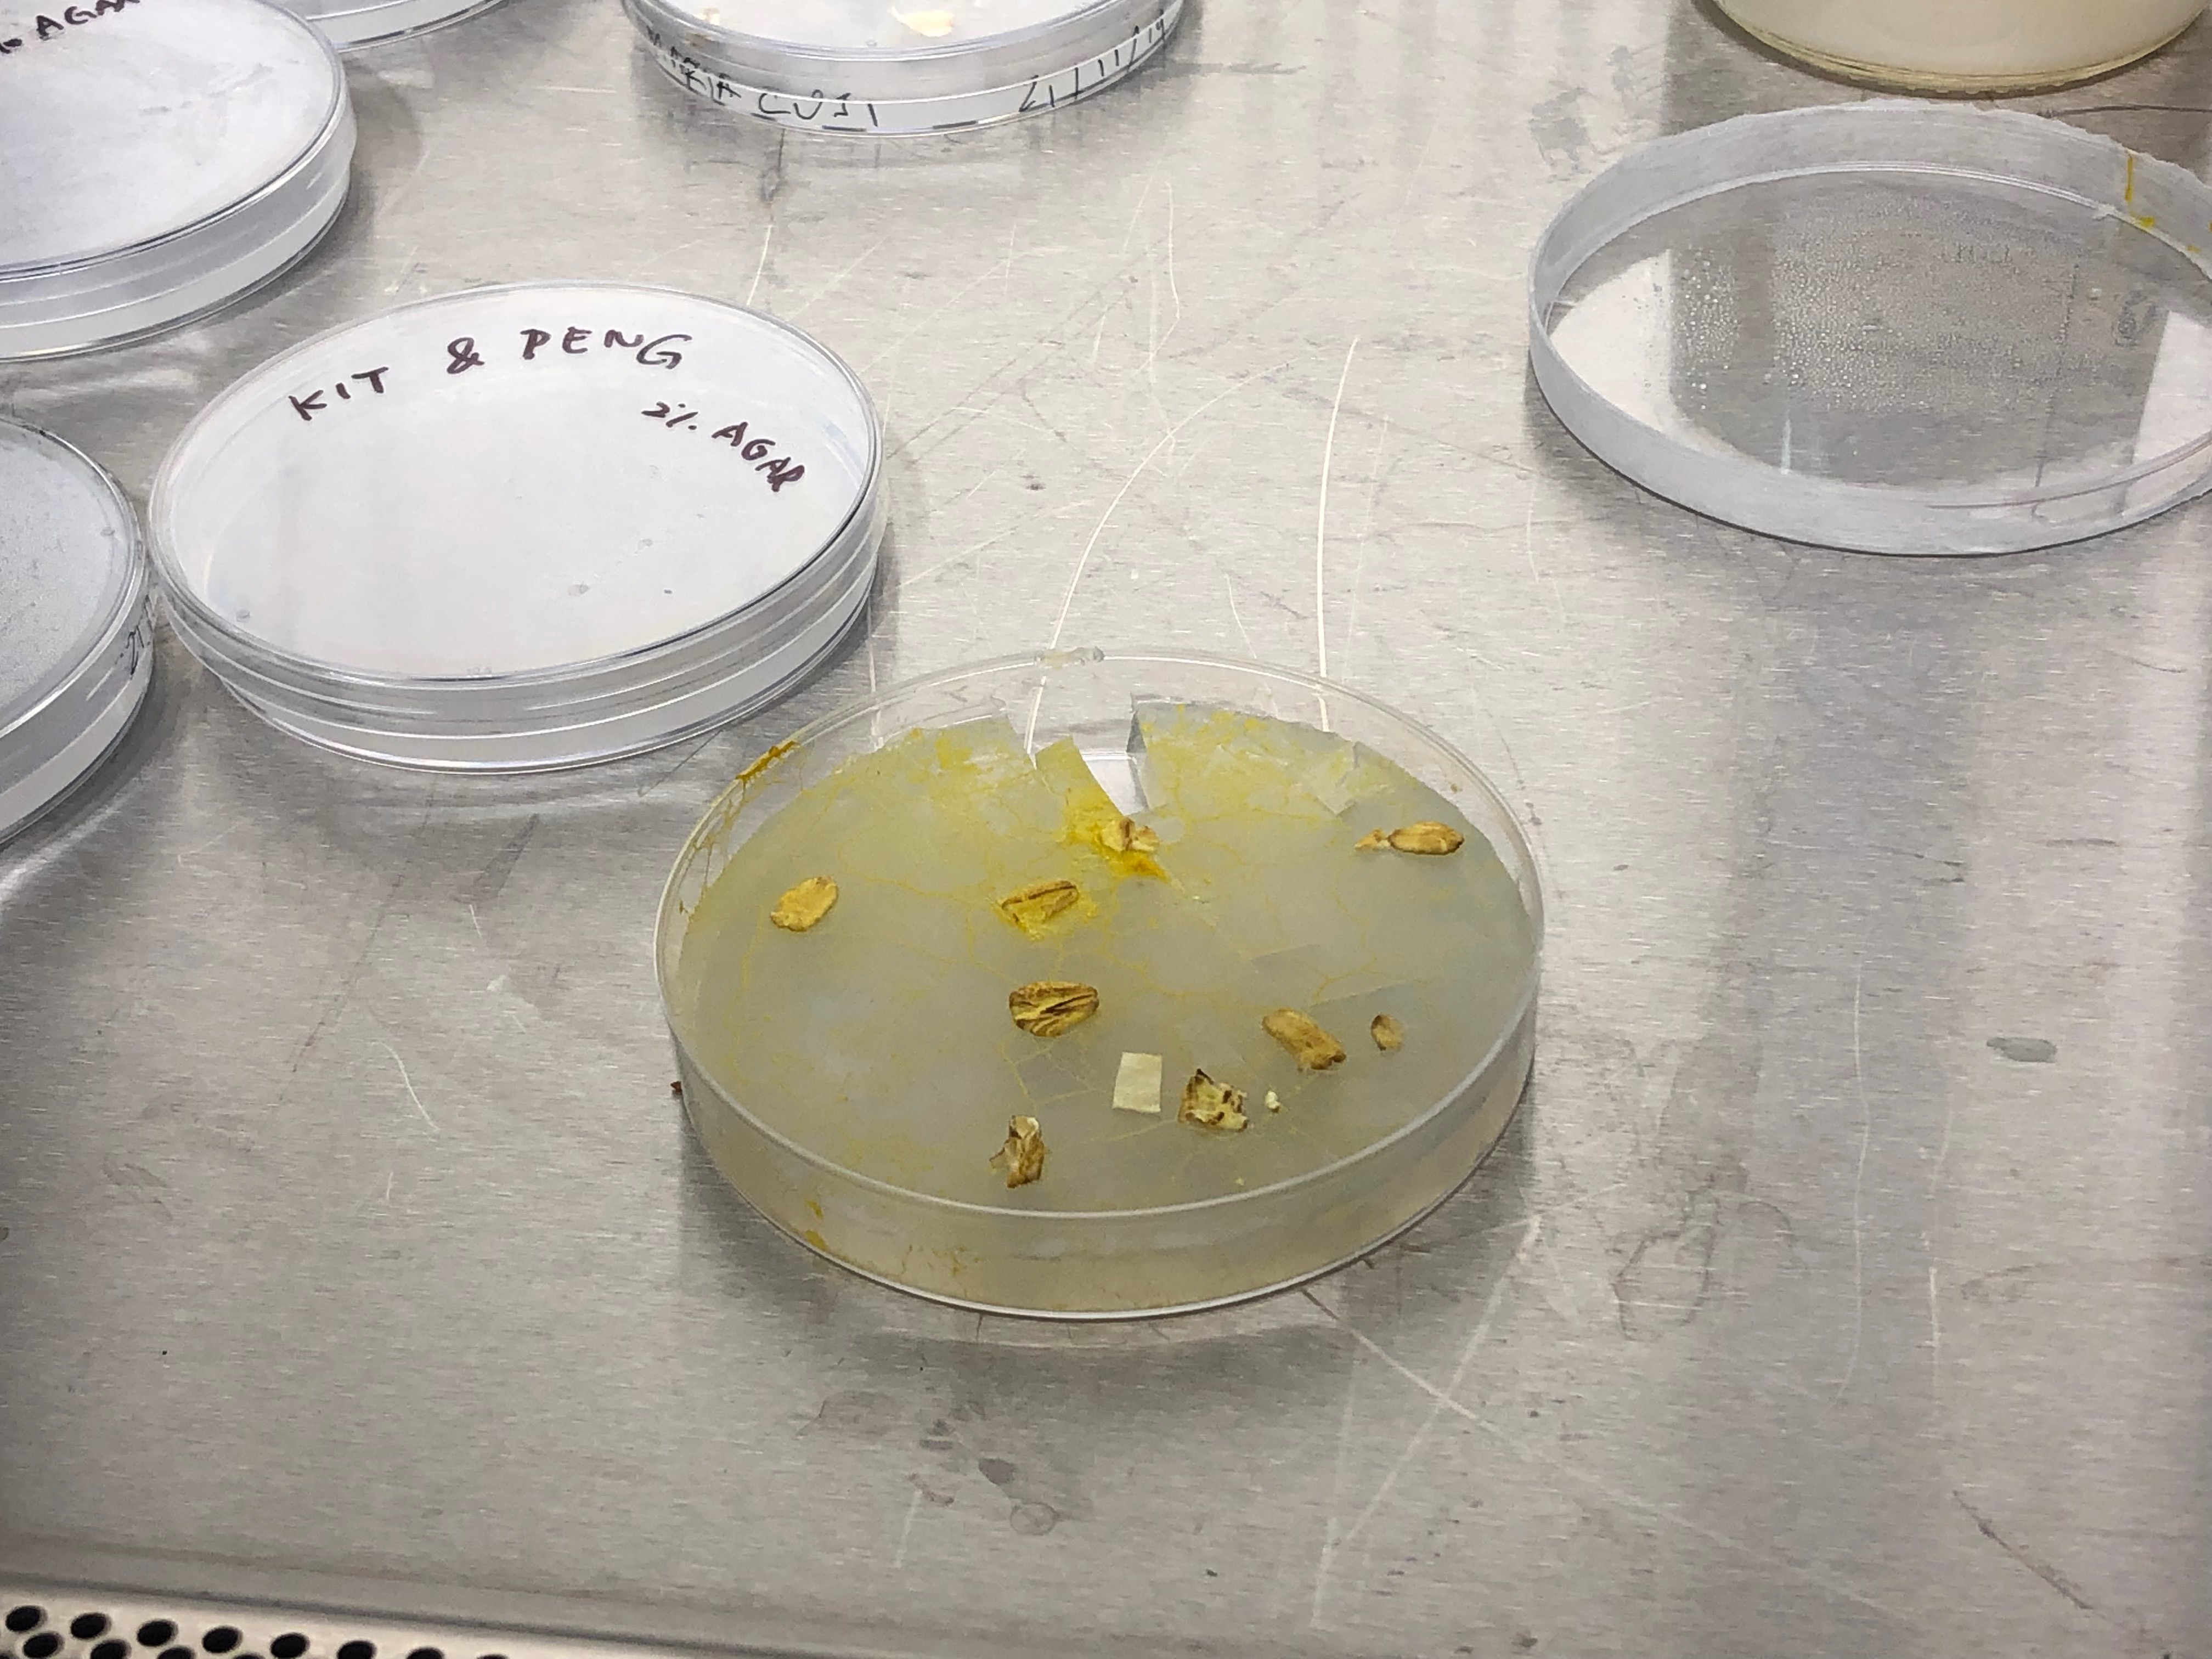
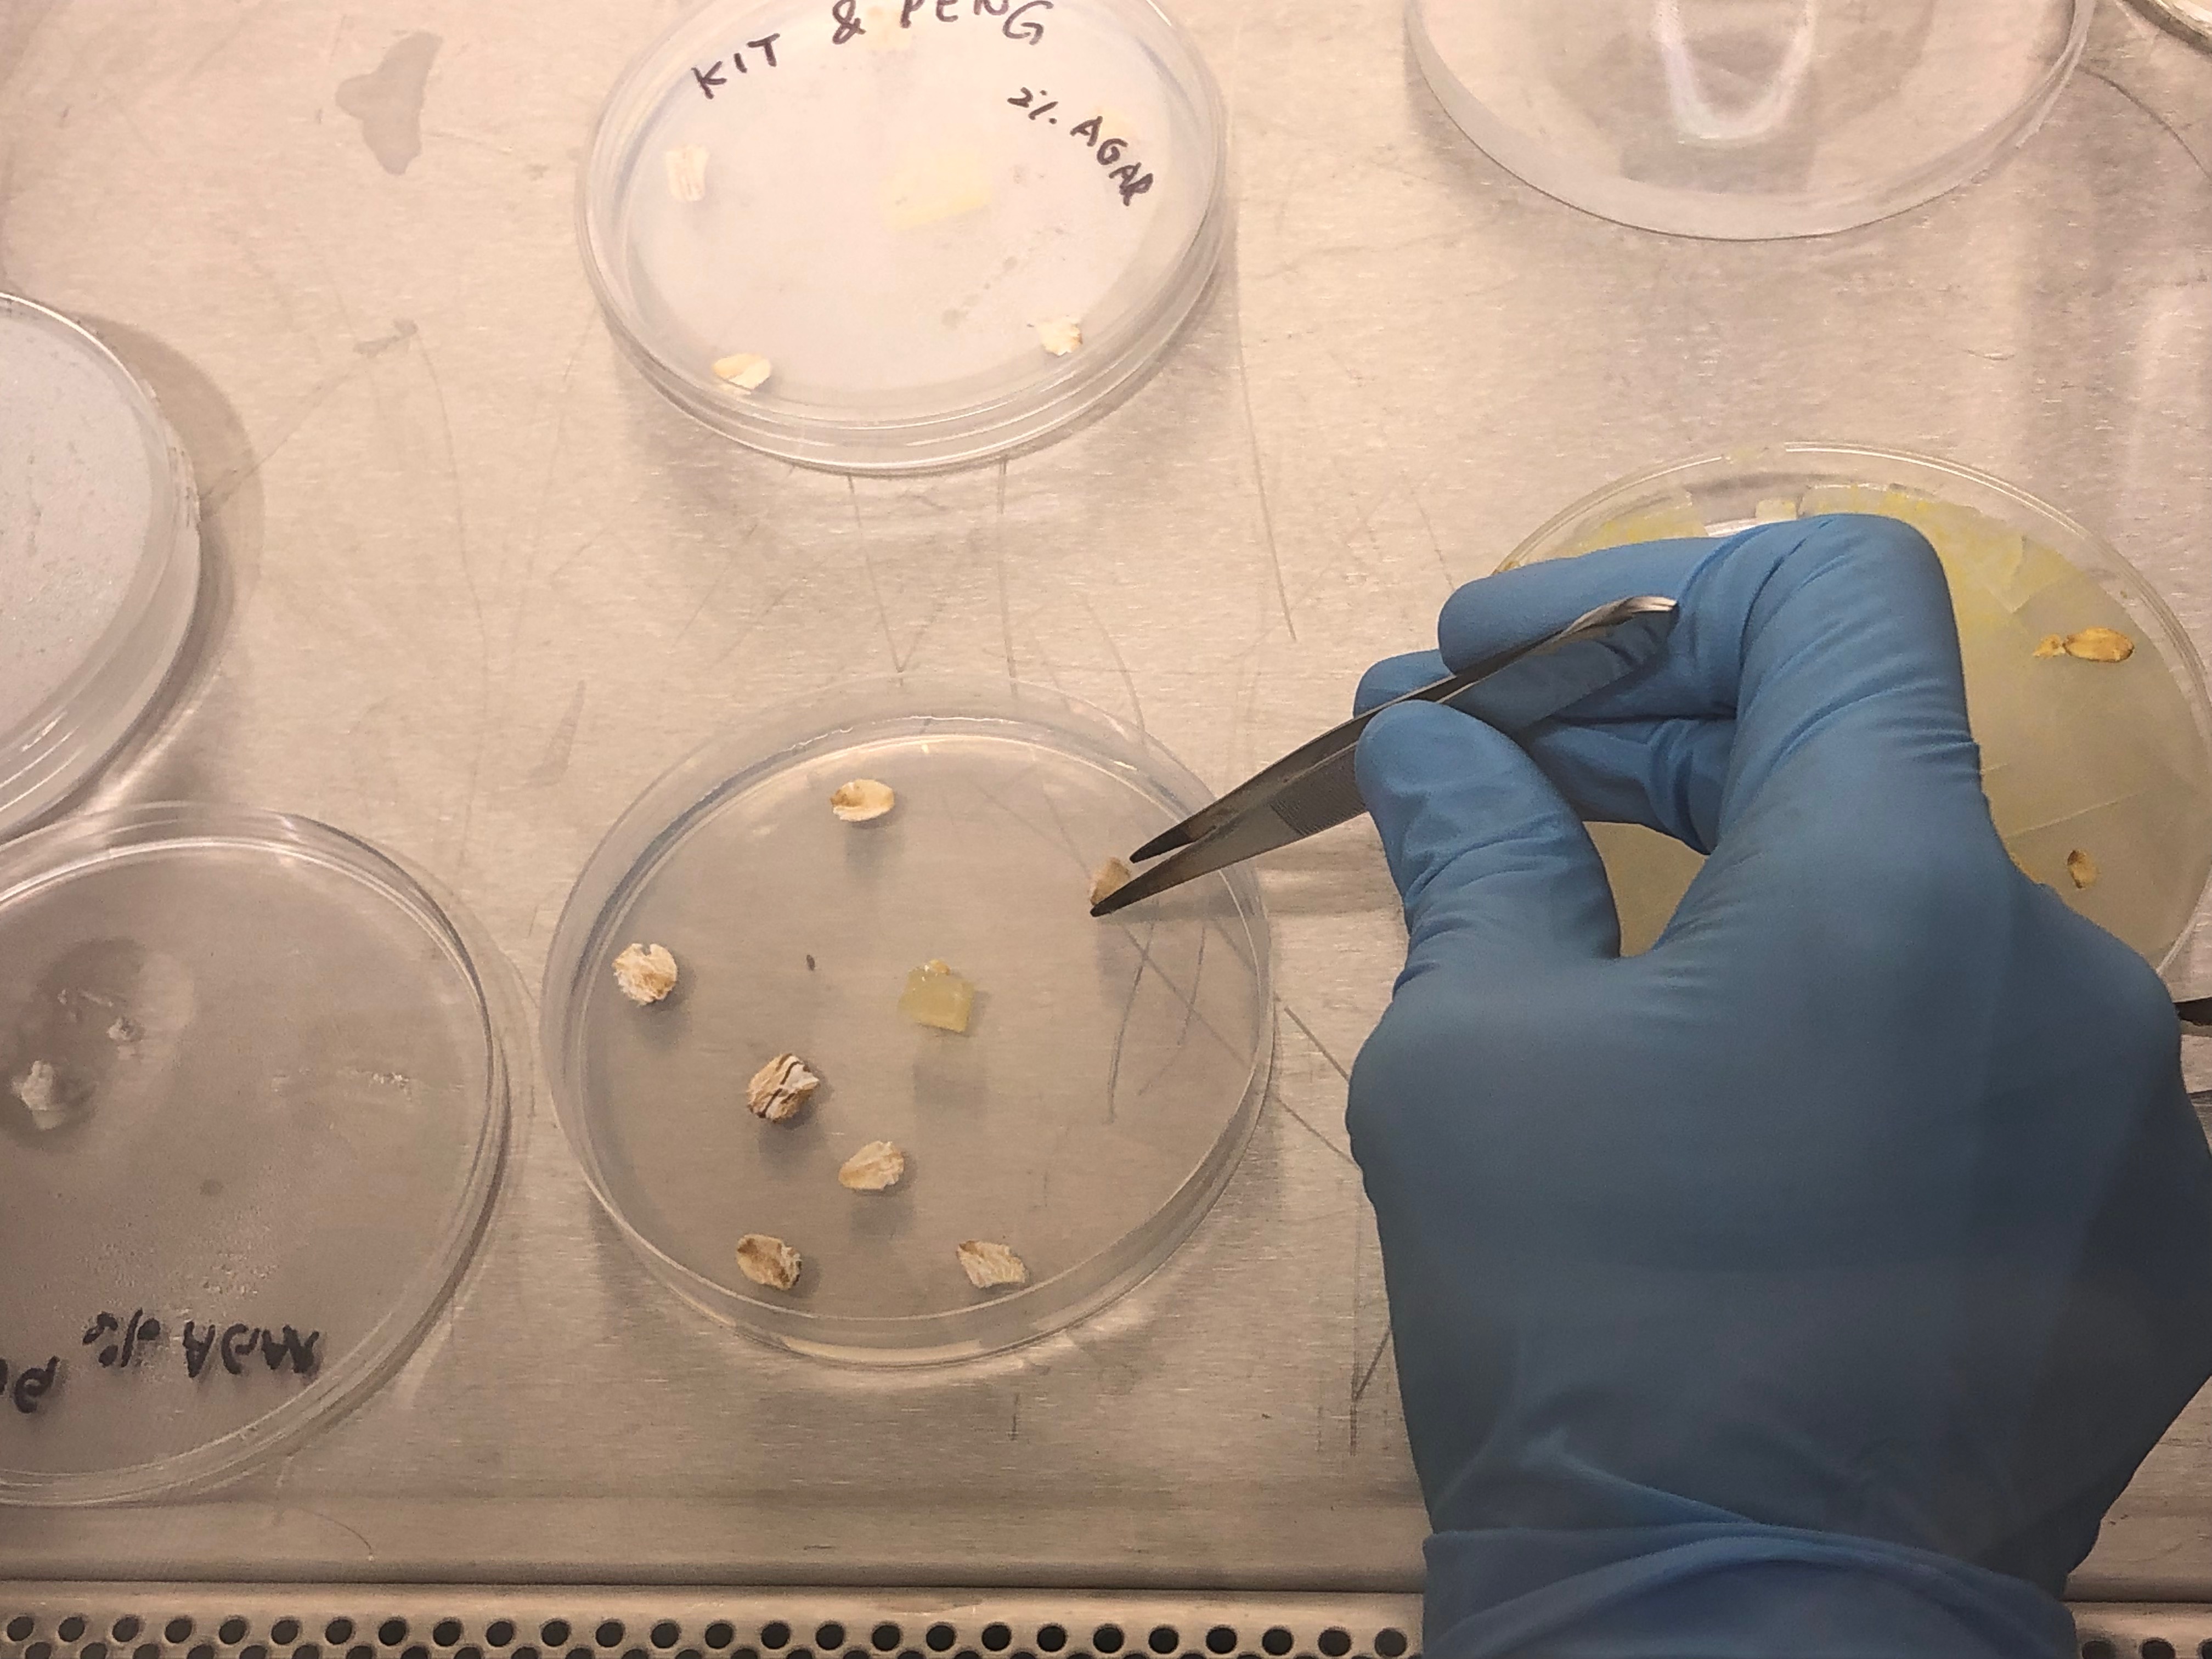

MAPPING SLIME MOLD
Using the image processing software, Fiji, to map the growth of Physarum Polycephalum
2019

Slime mold is an informal name given to several kinds of unrelated eukaryotic organisms with a life cycle that includes a free-living single-celled stage and the formation of spores. Spores are often produced in macroscopic multicellular or multinucleate fruiting bodies which may be formed through aggregation or fusion. More than 900 species of slime mold occur globally. Their common name refers to part of some of these organisms' life cycles where they can appear as gelatinous "slime".


Non-neural (without a nervous system) organisms like plants, fungi, bacteria that constitute the majority of living species on earth, have amazing capacity for decision-making and processing information in order to exploit their environment in a non-random, adaptive fashion.
Slime molds carry out an impressive biological function known as emergence where simple organisms obeying simple rules can collectively manifest astonishingly complex behaviour.

When slime molds are placed in a new environment they spread out in every direction in a fractal pattern, assessing their environment. If they find something beneficial to them, like nutrients, they will reinforce the pathway.
Chemotaxis is the directed migration of cells in response to concentration gradients of extracellular signals. In unicellular organisms, such as bacteria and amoebae, chemotaxis is frequently used as a foraging mechanism.
Observing Chemotaxis





Petri dishes innoculated with slime mold. Slime mold cutting in the centre (black rectangle) with oats dotted around (balck ovals). Created with Fiji, an image processing software.
Subculturing Slime Mold

Testing Chemotaxis & Observing Sporolation




Slime moulds can exist as free-floating single cells. But when two or more slime moulds meet, they dissolve the cell membranes that separate each individual strand and fuse together in one membrane. This means two individuals, with distinct genetic material, can exist within the same unified body. There is also no limit to the number of ‘individuals’ that can join the collective, called a plasmodium. Each cell of the slime mould is making decisions that ultimately benefit the collective organism.
Project coordinated with Meiqi Peng, MA Biodesign, CSM. 2019